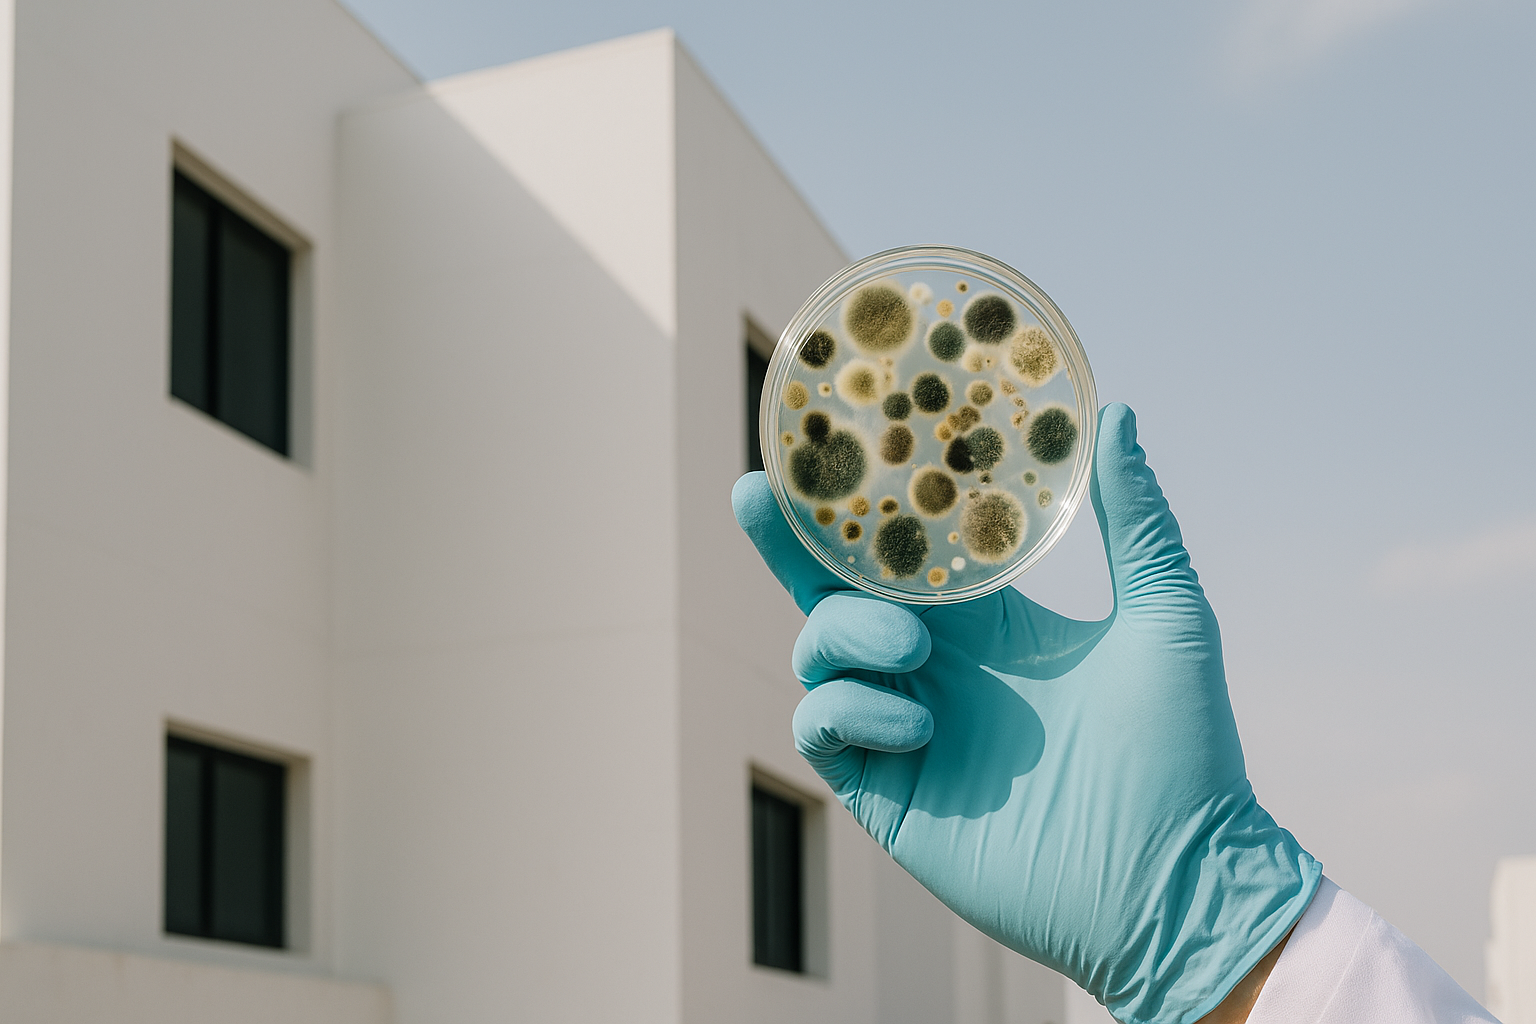

Table of Contents
Finding a reliable mold mycotoxin test near me Dubai service is crucial for maintaining a healthy and safe living or working environment in Dubai. Mold infestation poses serious health risks due to the presence of toxic mycotoxins, and understanding these dangers is the first step to taking effective preventive and corrective actions.
Understanding Mold and Mycotoxins
Mold is a type of fungus that thrives in moist environments—very common in regions like Dubai where humidity can fluctuate. While some molds are harmless, several species produce mycotoxins, hazardous compounds that adversely affect human health. Exposure to these toxins can cause respiratory issues, allergic reactions, and other chronic health problems. To accurately identify the extent of such issues, investing in a reliable mold mycotoxin test near me Dubai is highly recommended.
Mycotoxins can be present not only in visible mold colonies but also hidden inside walls, HVAC systems, carpets, and upholstery. Therefore, it is often challenging to identify mold problems without professional testing. This makes a mold mycotoxin test near me Dubai indispensable for accurate detection and risk assessment.
Why Mold Mycotoxin Test Near Me Dubai Is Essential
Dubai’s fast urban development and climate create conditions favorable for mold growth in buildings. Professional mold mycotoxin testing in Dubai is essential to safeguard homes, offices, and commercial spaces. For residents and businesses, understanding the critical need for a mold mycotoxin test near me Dubai is paramount. Here are the critical reasons why you should consider it:
- Accurate Identification: Specialized testing identifies mold species and detects harmful mycotoxins invisible to the naked eye.
- Health Protection: Detecting mycotoxins early helps prevent respiratory ailments and allergies that are rising concerns in the Dubai population.
- Regulatory Compliance: Dubai Municipality emphasizes indoor air quality. Testing ensures you comply with local health and safety regulations.
- Targeted Remediation: The test results guide effective treatment plans addressing the specific mold problem, avoiding unnecessary or ineffective interventions.
- Peace of Mind: Confirming a mold-free environment supports well-being and property value. For more detailed guidance, consider consulting a comprehensive guide to mold mycotoxin test near me Dubai.
Top Mold Mycotoxin Testing Services in Dubai
Searching for a mold mycotoxin test near me Dubai leads you to specialized companies dedicated to indoor environmental safety. In Dubai, services provide detailed mold and mycotoxin testing, and you can find comprehensive information on obtaining a reliable mold mycotoxin test near me Dubai through specialized companies using advanced sampling methods such as air, surface, and bulk material analysis.
Locally, Saniservice Dubai offers expert testing and remediation strictly within Dubai. Their technicians are certified and equipped to assess various properties, including residential, commercial, and industrial sites across Downtown Dubai, Business Bay, Dubai Marina, Meadows, and Arabian Ranches.
The combined knowledge of these services ensures:
- Compliance with Dubai Municipality’s indoor air quality standards
- Use of UAE-approved collection and lab techniques strictly for Dubai
- Comprehensive reporting with actionable advice
Effective Mold Treatment Options Available in Dubai
Once a mold mycotoxin test near me Dubai confirms the presence of mold and mycotoxins, selecting an appropriate treatment is vital. Effective mold remediation in Dubai includes a variety of methods tailored to the specific mold problem and property conditions. Here are proven approaches:
Physical Removal
This involves professional cleaning and removal of contaminated materials such as drywall, carpets, and insulation. Trained technicians use containment to avoid spreading spores during removal. This method is ideal for areas with visible mold growth and damaged materials.
Chemical Treatment
Application of EPA- and Dubai Municipality-approved antifungal agents helps kill mold spores on surfaces and prevents regrowth. These treatments are typically executed after physical removal to sanitize affected areas thoroughly.
Humidity and Ventilation Control
Controlling indoor humidity by improving ventilation and using dehumidifiers reduces mold-friendly environments. DEWA’s recommendations encourage managing moisture sources, particularly in high-humidity Dubai locales like Dubai Marina and Meadows.
Advanced Technologies
Innovative options such as thermal fogging and ozone treatments are sometimes applied for comprehensive sterilization of indoor air and surfaces after standard remediation.
| Treatment Type | When to Use | Benefits |
|---|---|---|
| Physical Removal | Visible mold with damaged materials | Eliminates mold source and contaminated materials |
| Chemical Treatment | After removal for surface sanitization | Kills residual spores and prevents regrowth |
| Humidity Control | In all mold-prone areas | Prevents mold reappearance by moisture regulation |
| Advanced Technologies | Severe infestations or sensitive environments | Deep sterilization of air and surfaces |
Regular follow-up after remediation is also crucial, and a subsequent mold mycotoxin test near me Dubai can confirm the effectiveness of the treatment, ensuring lasting safety.
Choosing the Right Service Provider in Dubai
Selecting a trustworthy and experienced provider for your mold mycotoxin test near me Dubai is vital for accurate results and effective remediation. Consider these practical tips when choosing your provider in Dubai:
- Certification and Expertise: Confirm the company has professional accreditations recognized by Dubai health authorities such as Dubai Municipality or DHA.
- Local Experience: Providers with a focus strictly on Dubai, like Saniservice, understand local building materials and climate challenges.
- Comprehensive Reporting: Look for services that provide clear, detailed test results with remediation guidance.
- Customer Reviews: Positive feedback from Dubai residents or businesses is a good indicator of reliability and quality.
- Environmental Commitment: Choose companies using safe, approved chemicals and responsible disposal methods.
Conclusion and Call to Action
Ensuring your living or working space is free from hazardous mold and mycotoxins starts with choosing a reliable mold mycotoxin test near me Dubai. The health benefits, regulatory compliance, and peace of mind it provides are invaluable in the dynamic Dubai environment. By opting for professional testing and appropriate remediation methods, such as those offered by recognized providers, you take a proactive step toward a safer indoor environment.
Don’t wait until mold symptoms affect your health or property value. Contact a trusted testing service today to arrange your mold mycotoxin test near me Dubai and protect your home or business effectively.
Comprehensive Guide to Finding a Reliable Mold Mycotoxin Test Near Me Dubai
When it comes to indoor air quality and health in Dubai residences or commercial properties, identifying the presence of harmful mold and its associated toxins is crucial. Mold contamination can originate from various sources such as water damage, high humidity, or improper ventilation—common issues in parts of Dubai’s climate and construction environment. To effectively protect your family, tenants, or employees, conducting a mold mycotoxin test near me Dubai is a vital first step.
Understanding mold mycotoxins and locating an accredited and trustworthy testing provider in Dubai ensures the safety and well-being of occupants while helping property owners comply with Dubai Municipality and Dubai Health Authority (DHA) environmental and health safety standards.
What Are Mold Mycotoxins and Why Testing Matters
Mold mycotoxins are toxic compounds produced by certain mold species that thrive in damp or poorly ventilated environments. These microscopic toxins can become airborne or settle on surfaces, posing significant health risks when inhaled or ingested over time. Common symptoms linked to mold mycotoxin exposure include respiratory issues, allergic reactions, headaches, fatigue, and in some sensitive individuals, more severe immune system disturbances.
In Dubai buildings, especially newer developments in areas like Business Bay, Jumeirah, or Nad Al Sheba, where interiors may be highly insulated but ventilation is limited, mold problems can go unnoticed until symptoms arise. Consequently, reliable testing goes beyond identifying visible mold—it detects the presence and concentration of mycotoxins to assess the indoor environment accurately.
Types of Mold Mycotoxin Tests Available in Dubai
Depending on the provider, mold mycotoxin testing in Dubai typically includes one or more of the following methods:
- Air Sampling: Collects airborne mold spores and mycotoxin particles to analyze indoor air quality in homes or workplace buildings.
- Surface Swabs and Tape Lifts: Samples mold residues from visible or suspected contaminated surfaces.
- Bulk Material Sampling: Includes testing of insulation, drywall, carpets, or HVAC system components where mold can hide.
- Laboratory Mycotoxin Assays: Advanced chemical and molecular techniques used by accredited UAE labs to identify specific toxin types and concentrations, aligning with Dubai Municipality standards.
These testing approaches align with environmental standards recommended by Dubai Municipality’s Guidelines on Indoor Air Quality and MOHAP’s health directives, ensuring outcome reliability and regulatory compliance.
Choosing a Mold Mycotoxin Test Near Me Dubai: Factors to Consider
With multiple providers in Dubai offering mold mycotoxin testing services, it’s essential to select one that fits your needs while guaranteeing accuracy and professional handling. Here are some key criteria:
- Accreditation and Certification: Verify that the testing company and laboratory follow Dubai Municipality and DHA protocols. Accreditation from UAE-based agencies or ESMA-backed standards further confirms quality control specific to Dubai.
- Experience in Dubai’s Climate: Mold growth patterns in Dubai’s arid yet periodically humid environment require specialized knowledge of local building materials and ventilation challenges.
- Comprehensive Reporting: Ask if the test results include not only mold species identification but also mycotoxin levels and recommendations aligned with Dubai’s environmental health guidelines.
- Response and Remediation Partnership: Some labs or consultants provide follow-up support for mold remediation consistent with Dubai Fire & Life Safety Code and Dubai Municipality’s cleanliness and safety regulations.
Where to Find Trusted Mold Mycotoxin Testing Services in Dubai
For residents and businesses searching online for “mold mycotoxin test near me Dubai,” several Dubai-based companies specialize in environmental diagnostics specifically tailored to the city’s unique conditions. These companies often serve neighborhoods like Downtown Dubai, Dubai Marina, Arabian Ranches, and Al Barsha, providing prompt sample collection and digital reporting for quick action.
Many providers work closely with Dubai’s health authorities and follow stringent procedures driven by DHA guidelines to ensure the safety of both sampling technicians and property occupants during the process.
Preparing for Your Mold Mycotoxin Test
Once you book a test, there are simple steps you can take to ensure accurate and effective sampling within your Dubai property. Ensuring proper preparation for your mold mycotoxin test near me Dubai will lead to the most accurate results.
- Maintain typical use of the area to reflect authentic indoor air conditions, avoiding any temporary ventilation or cleaning that could skew results.
- Ensure easy access to HVAC systems, storage areas, or rooms with visible water damage for comprehensive inspection.
- Notify occupants about the test date to minimize interference and allow safe sampling procedures in line with Dubai workplace safety practices.
Test preparation guidance is usually provided by the service provider and is aligned with Dubai Municipality’s health and safety management protocols.
Post-Test Steps: Understanding Results and Ensuring Safety
Receiving your report on mold mycotoxin presence allows you to make informed decisions. A detailed result from a certified Dubai lab will include:
- Identification of mold species detected
- Quantitative levels of toxins measured
- Comparisons against Dubai Municipality’s acceptable indoor air quality limits
- Recommended remediation and preventive measures tailored for Dubai’s environment
Following these guidelines minimizes the risk of prolonged exposure and supports compliance with Dubai municipality health regulations. When necessary, professional remediation services in Dubai can be engaged to safely remove mold and treat contaminated areas to prevent recurrence. Ultimately, the goal of every mold mycotoxin test near me Dubai is to ensure a safe and healthy environment for all occupants.
Why Regular Mold Testing Is Vital in Dubai
Dubai’s unique interplay of arid climate and indoor climate control systems means mold outbreaks can arise silently, especially in properties with irrigation, fountains, or water features common in Dubai’s luxury developments. Regular testing for mold mycotoxins helps:
- Detect hidden hazards before visible mold growth appears
- Protect vulnerable individuals such as children, seniors, or people with respiratory conditions
- Maintain property value by preventing structural damage from mold
- Ensure compliance with Dubai Municipality and DHA health and safety codes
Whether you live in older neighborhoods like Jumeirah or newer communities such as Meydan or Dubai Hills, proactive mold mycotoxin testing is a wise investment in your health and Dubai property upkeep.
Conclusion
Searching for a “mold mycotoxin test near me Dubai” uncovers an abundance of specialized local services committed to protecting residents and businesses from the hidden dangers of mold contamination. By selecting accredited providers familiar with Dubai’s environment and standards, you ensure precise testing that complies with DHA and Dubai Municipality requirements.
Regular mold mycotoxin testing is an essential part of maintaining healthy indoor air quality throughout Dubai’s diverse real estate, from Downtown offices to family homes in Arabian Ranches. With trusted experts and comprehensive testing methods, you can effectively safeguard health, comply with regulatory frameworks, and enjoy a safer indoor environment in Dubai.